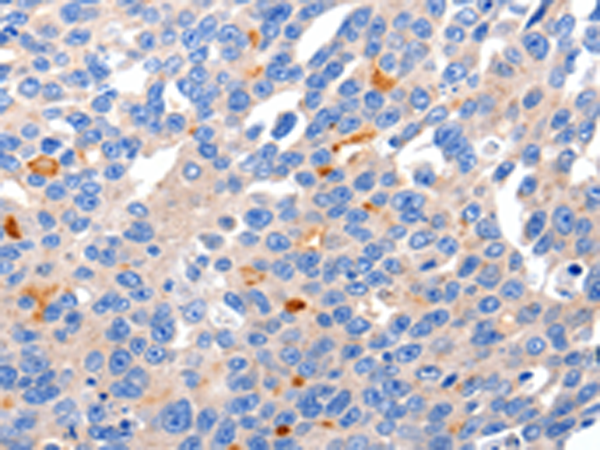

-
分类: 科研抗体货号: P10910别名: ADF, AGEL应用: IHC反应种属: Human, Mouse, Rat
-
分类: 科研抗体货号: P10942别名: BCNG2, HAC-1, BCNG-2应用: IHC反应种属: Human, Mouse, Rat
-
分类: 科研抗体货号: P10929别名: GLUR3, mGlu3, GPRC1C, MGLUR3应用: WB反应种属: Human, Mouse, Rat
-
分类: 科研抗体货号: P10941别名: BCNG1, HAC-2, BCNG-1应用: WB,IHC反应种属: Human, Mouse, Rat
-
分类: 科研抗体货号: P10928别名: ACCA应用: WB反应种属: Human, Mouse, Rat
-
分类: 科研抗体货号: P10940别名: ELK, ELK1, elk3, Kv12.1应用: IHC反应种属: Human, Mouse, Rat
-
分类: 科研抗体货号: P10963别名: AFBP; IBP1; PP12; IGF-BP25; hIGFBP-1应用: IHC反应种属: Human
-
分类: 科研抗体货号: P10939别名: BEC1, ELK2, Kv12.2应用: IHC反应种属: Human, Mouse, Rat
-
分类: 科研抗体货号: P10962别名: RAI, RAI4, IASPP, NKIP1应用: WB,IHC反应种属: Human, Mouse
-
分类: 科研抗体货号: P10938别名: GCH, DYT5, DYT14, DYT5a, GTPCH1, HPABH4B, GTP-CH-1应用: WB,IHC反应种属: Human

鄂公网安备42018502007531号
鄂公网安备42018502007531号

